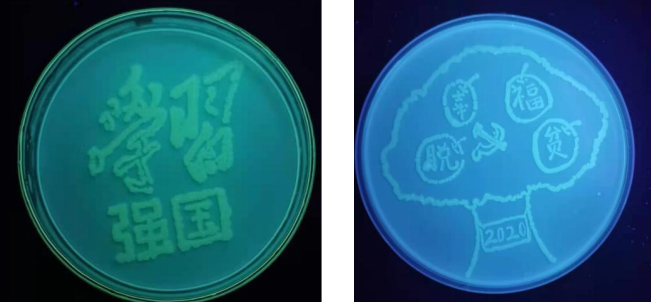

编者按:248cc永利集团党委秉持“党建引领、创新驱动、服务师生、全面发展”理念,以“一总支一品牌”为抓手,充分挖掘基层党组织工作亮点与优势,持续在优化组织设置、强化队伍建设、丰富活动载体、完善工作机制等方面发力。为进一步推进学院基层党建工作品牌建设,发挥典型示范引领作用,营造基层党组织形成“百花齐放”的浓厚党建氛围。学院党委决定宣传、推广一批基层党建优秀案例,案例将分期推出,供各基层党组织交流学习。
一、基本情况
中共248cc永利集团理工学科部教工联合支部共有正式党员6人,研究生学历6人,高级职称6人。支部获得2024年南昌大学优秀基层党组织,支部参与建设国家级科技小院1项,支部书记为教师党支部书记“双带头人”,1人获得全国大学生先进成图与产品信息建模创新大赛优秀指导教师,2人次获得江西省大学生科技创新竞赛优秀指导教师,3人次为优秀共产党员,2人次在教师授课大赛获一等奖,1人获得学院“最美教师”称号,4人获得工程训练优秀教师等多项奖励。本支部是以中青年教师为主的朝气蓬勃的党员队伍,团队思想道德品质好,教学能力强,教学经验丰富,教学特色鲜明,以服务地方发展为特色的基层党支部。
二、主要做法
充分发挥三方资源优势,实现党建、专业、服务融合发展。高校侧重人才养育和知识服务、地方基层党组织侧重政策与资源支持、企业方侧重实践项目与平台供给,共同营造以高质量党建推动业务高质量发展的体制机制,实现多方协同发展。
(一)政治理论联学
教工联合支部充分发挥政治理论强、专业知识扎实、授课能力强的优势,与地方基层党组织定期开展政治理论联学,结合地方党组织在基层治理中的实际工作,讲好红色中国故事,将党的先进理论与身边事联系起来,实现问题导向式研学。通过以学促建,既强化对地方基层党员的思想教育,提升从习近平新时代中国特色社会主义思想中汲取力量,不断推动新质发展的能力。又以实际案例为引领,使学生真学、真信、真用党的先进理论,从而更加坚定“四个自信”,自觉做到“两个维护”。到目前为止,教工联合支部实现了平均每月1次的校地基层党组织的联学工作,实现了与地方基层党组织在党建工作上的深度合作,结对共发展,定期交流党建工作经验,形成资源共享、优势互补的党建联建的目标。见图(1-2)。

(图1:教工联合支部到关帝庙村党支部进行党建活动,并在支部书记蔡红生的带领下,到蔬菜种植大户家中,针对农产品的季节销售问题,进行了沟通交流,并计划在2024年下半年为该村进行网络销售和直播培训。)

(图2:教工联合支部、九江市农业技术推广中心党支部在共青城市跃进村党支部的带领下,到跃进村昌泰农业的现代化草莓种植园进行支部共建活动。此前曾为该种植园捐献约1000株草莓新品种,此次活动主要为草莓的生长过程的病虫害防治做指导。)
(二)理论实践结合
校-企基层党组织联建实践基地,充分发挥企业实践优势,以国家级“科技小院”项目建设为平台,让学生运用专业所学,在农业农村的广阔舞台上挥舞青春力量。通过以做促学,既为乡村振兴注入科技力量,又让学生真实感受为人民服务的深刻内涵,将党课上在乡村田野上,让他们在攻坚克难中不断锤炼思想、提升力量真正成长为有意愿、有能力担当民族复兴大任的时代新人。见图3。

(图3 教工联合支部深入到共青城市农村一线,为当地的果蔬种植园进行科技指导。此活动目前基本实现每月1次。)
(三)项目合作运营
校-地-企联合开展实际项目运作,发挥地方党组织的政策优势、对接企业的发展需求,发挥高校科技、人才聚集优势,协同开展科普教育、脱贫攻坚、产品开发、技术推广、环境保护等项目。以党建共建为纽带,以实战项目为平台,融合推动社会进步、企业发展与人才成长,实现良性互动多赢,真正实现党建业务协同发展。见图4。

(图4 教工联合支部经过多年与地方企业的合作,在2024年上半年,作为共建单位,完成了国家级科技小院的申请,为校企进一步合作奠定了基础。)
(四)校企联合开发
凝炼校-地-企党建共建过程中的实际成果,建设课程思政案例库。教工联合支部带领学生多次走进企业,为企业解决实际问题,提供切实可行的解决方案。这种一线的工作经验,使得学生们能够更好地将所学知识进行落地,真正应用到实际工作中去。同时,学生们也深刻认识到,知识并不是孤立存在的,而是用来服务于社会、服务于人民的。以榜样力量铸牢青年学子学成报国的理想信念,落实“为党育人、为国育才”使命任务。以此为基础进行“校企合作”一流本科课程的孵育,实现素质高、能力强、有信念的高质量人才供给,服务新质发展。见图5-6。

(图5 教工联合支部为进一步为地方发展服务,针对地方企业提出的问题进行有针对性的解决。图为支部书记吴红静带领团队到企业进行产品取样。)
支部书记多次带领团队以及生物工程、制药工程专业的大学生们,到相关企业开展科技服务活动。团队不仅对企业进行了深入的考察和调研,更针对共青城市杨梅这一特色水果,对杨梅酒产品的各项关键指标开展测定工作,同时也对杨梅果酒的生产工艺实施优化升级。并设计了一系列富有创意和趣味的产品,包括“喜上梅梢、梅开眼笑、梅你不行、梅关系、梅烦恼”等,这些产品名称既体现了杨梅的独特魅力,也彰显了大学生在服务农业时的巧妙心思。



(图6 在教工党支部的带领下,我校学生为企业设计的专属Logo。Logo融合了杨梅的元素和特点,既具有辨识度,又富有创意,为这些产品增色不少,并依据杨梅园总负责人李良武同志的形象,设计了一套卡通人物形象。这些工作为杨梅的深度加工产品宣传做了早期规划,为企业的发展和壮大提供了强有力的支持。2024年在团队的帮助下,杨梅生产销售旺季,共销售杨梅及其制成品约170万元,较去年同期相比增长了17 %,种植户人均收入达2万元。)

(图7 教工联合支部带领学生为企业设计的新产品)
团队帮助企业申请抖音账号,并且提供专业的培训,使其掌握抖音直播等相关技能,包括如何使用抖音平台,如何进行直播,如何与观众互动,如何推广自己的产品等内容。通过这些培训,使得企业将能够更好地利用抖音这个平台,提升产品的知名度和销售额。


(图8 为更好的了解本地资源,教工联合支部带领学生完成共青城市珍珠湖种质资源资源调查和入侵物种现状调查。)
通过多种类似的活动,加强高校基层党组织与农业基层之间的联系,进一步促进科技与农业的深度融合,提升科技对农业的服务质量和效率。这样的活动也为科技服务农业开辟了新的途径,展示了科技在推动农业现代化进程中的重要作用。科技特派团的活动也受到了江西省农技协、江西省院士专家服务中心等专家的高度赞扬和评价。
(五)育人与党建结合
教工党支部将相关课程与当前社会热点相结合,利用红色教育完成课程实验,即提高了学生的创作兴趣,又拓展了学生的知识应用能力。例如“庆祝建党 100 周年”为主题的实践活动中,生工班的学生以“微生物画”的方式创作出了“百年”、“学习强国”等作品(见图9-10),获得了一致好评,并获得了全国青年科普创新实验暨作品大赛(江西省赛区)三等奖。该项目实施后,激发了更多学生对微生物学习的兴趣,原本不受欢迎的代谢途径也变得炙手可热起来。实验课程由原来老师逼着做,转变为“我想做”,“我能做”的局面。

(图9 生物工程班学生为建党百年设计的“百年”微生物画,通过“为人民服务”、“不忘初心”、“星星之火,可以燎原”等内容,展现党的历史。该图采用沙雷氏菌,经微生物筛选、设计图案、无菌培养等实验步骤,肉眼观察到的图。)
(图10 熠熠发光的“学习强国、幸福脱贫”。说明:由学生采用基因工程手段,将荧光蛋白基因导入大肠杆菌,经培养后在荧光下观察到的图案。)
(六)科普与专业知识相结合
多次开展的“青春助力膳食·健康走进乡村”等类似的相关暑期社会实践活动,让大学生了解国家的惠农政策,了解国家的发展政策,是很好参与政治学习的途径。生物和制药专业的学生在下乡活动中,了解空巢老人、留守儿童、农村等一些问题,在学校、敬老院等地方广泛开展健康饮食、文明餐桌礼仪以及合理膳食相关知识的宣讲,开展“营养精准扶贫”工作,帮助当地居民拥有更加健康的生活方式和良好的饮食习惯,营养健康宣教活动受到了当地居民的大力欢迎(见图11和图12)。该项目也得到了了相关媒体报道。

(图11 在横峰小学为学生开展营养科普(左图);入户开展营养精准扶贫(右图))

(图12 为当地敬老院开展体格测量与营养指导)
三、工作成效
探索、总结地方高校基层党组织“双带头人”支部发挥示范引领作用的工作经验,以项目为引领,以结果为导向,在以专业优势助力乡村振兴发展的实践中,不断充实和完善以“资源共享、优势互补、协同作战”为导向的“校-地-企”基层党建合作发展模式,一是引领广大青年学子在建设红色大地的伟大事业中攻坚克难,切实提升人才培养内涵质量,服务地方经济社会发展。二是在实战中淬炼基层党组织的组织力、凝聚力和战斗力,实现党的先进理论在基层落地见效,引导科技、人才扎根农业农村广阔天地,实现基层党建、人才培养和乡村振兴融合发展。
在实际工作中,我支部取得了以下成效:
1. 2024年7月,入选创建第五批中国农技协(江西)科技小院名单,推荐单位:江西省农业专业技术协会、江西省院士专家服务中心;
2. 2024年7月,李敏同志荣获学院优秀共产党员称号;
3. 2024年8月,荣获首批江西省科协科技小院共建单位,颁发单位:江西省科学技术协会。
4. 2024年8月,理工学科部教工联合支部荣获南昌大学先进基层党组织;
5. 2024年4月在科技核心《生命的化学》发表《细目表在生物化学教学中的应用实践》(课程思政);
6.2024年度江西省高校党建研究项目:高校基层党组织“校-地-企”党建共建长效机制的研究,项目编号:24DJZD014。
7.2024年院级课题:高校基层党组织“融合共建机制研究,共青杨梅酿酒酵母代谢特性及发酵优化研究,
8.支部书记和支部党员多人次被评为“优秀共产党员”称号。
四、经验启示
1.提升基层党组织的工作效能和拓展基层党组织在校地企工作中的作用。
2.推动校企合作和产教融合:校企党建共建模式有助于深化产教融合,促进教育与产业的紧密结合,提高人才培养的质量和针对性。教工联合支部经过多年的摸索,探索出适合本专业的校企合作方式,和企业充分发挥各自的优势,充分利用学校的科研力量和人才资源,推动地方产业的升级和技术创新,提升地方经济的整体竞争力。
3.推动地方学校与当地政府、企业的紧密结合,致力于服务于当地经济社会的发展,通过多方合作,实现资源共享、优势互补,共同促进地方教育与经济的良性互动。目前教工党支部主要服务于学校周边的乡镇和村庄3个,企业7家,长期党建结对共建的支部3个,通过多方合作,实现资源共享、优势互补,共同促进地方教育与经济的良性互动。
4.工作经验总结形成的研究报告,将促进党建工作与学校、企业等单位的业务工作深度融合,实现共同发展,拓宽党建引领路径。
供稿单位:党委组织部(统战部)、理工学科部
作者:吴红静
图片来源:理工学科部教工联合党支部